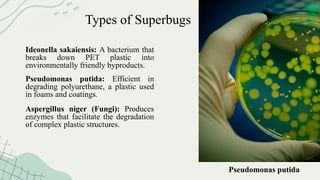
Types of Superbugs
Ideonella sakaiensis: A bacterium that
breaks down PET plastic into
environmentally friendly byproducts.
Pseudomonas putida: Efficient in
degrading polyurethane, a plastic used
in foams and coatings.
Aspergillus niger (Fungi): Produces
enzymes that facilitate the degradation
of complex plastic structures.
Pseudomonas putida

The document discusses the urgent issue of plastic pollution and presents biodegradable plastics and superbugs as potential solutions. Biodegradable plastics break down naturally unlike traditional plastics, while superbugs are genetically modified microorganisms capable of accelerating plastic degradation. The collaboration of these approaches offers a promising strategy for reducing environmental impact and addressing the plastic crisis.